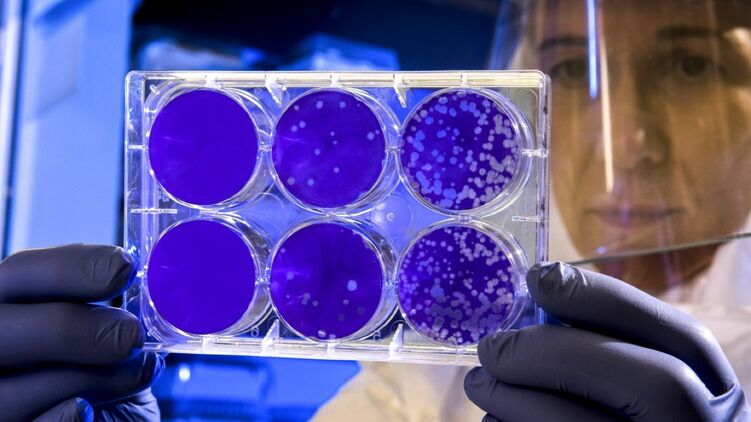

Штамм коронавируса "Омикрон" не является легким заболеванием - ВОЗ
Несмотря на то, что смертность от "Омикрона" оказалась на 75% ниже, чем от других видов коронавируса, во Всемирной организации здравоохранения (ВОЗ) утверждают, что новый штамм не является легким заболеванием.
Об этом заявил на брифинге гендиректор Всемирной организации здравоохранения Тедрос Адханом Гебрейесус.
"Хотя "Омикрон" действительно выглядит менее серьезным по сравнению с "Дельтой", особенно для вакцинированных, это не означает, что его следует относить к категории "легких". Как и в предыдущих вариантах, "Омикрон" приводит к госпитализации людей, и он убивает людей. Фактически, цунами случаев настолько огромно и быстро, что оно подрывает системы здравоохранения по всему миру", - сказал Гебрейесус.
Глава ВОЗ также добавил, что из-за "Омикрона" больницы становятся переполненными и недоукомплектованными, это влечет за собой смерти среди пациентов не только от ковида, но и от других болезней и травм, при которых пациенты не могут вовремя получить помощь.
Гебрейесус также призвал людей вакцинироваться и придерживаться противоэпидемических мер, а также настоял на равном распределении вакцин в мире.
"While Omicron does appear to be less severe compared to Delta, especially in those vaccinated, it does not mean it should be categorized as ‘mild’.
— World Health Organization (WHO) (@WHO) January 6, 2022
Just like previous [#COVID19] variants; Omicron is hospitalizing people and it is killing people." says @DrTedros. pic.twitter.com/7QZxMSvZ6q
Напомним, ранее мы писали о том, что две дозы вакцины "Sinovac" и бустерная от "Pfizer" не оправдали ожидания медиков и показали низкий уровень иммунной защиты против штамма коронавирусной инфекции "Омикрон", ключевые симптомы которого недавно раскрыли ученые. Деятели научной сферы заявили, что эффект этих препаратов аналогичен курсу мРНК-вакцины.
Мы также сообщали о том, что Центр по контролю и профилактике заболеваний США рекомендует при некоторых симптомах штамма коронавируса "Омикрон" срочно обращаться в больницу. Речь идет, в частности, об изменении цвета губ, затрудненном дыхании и спутанности сознания.















